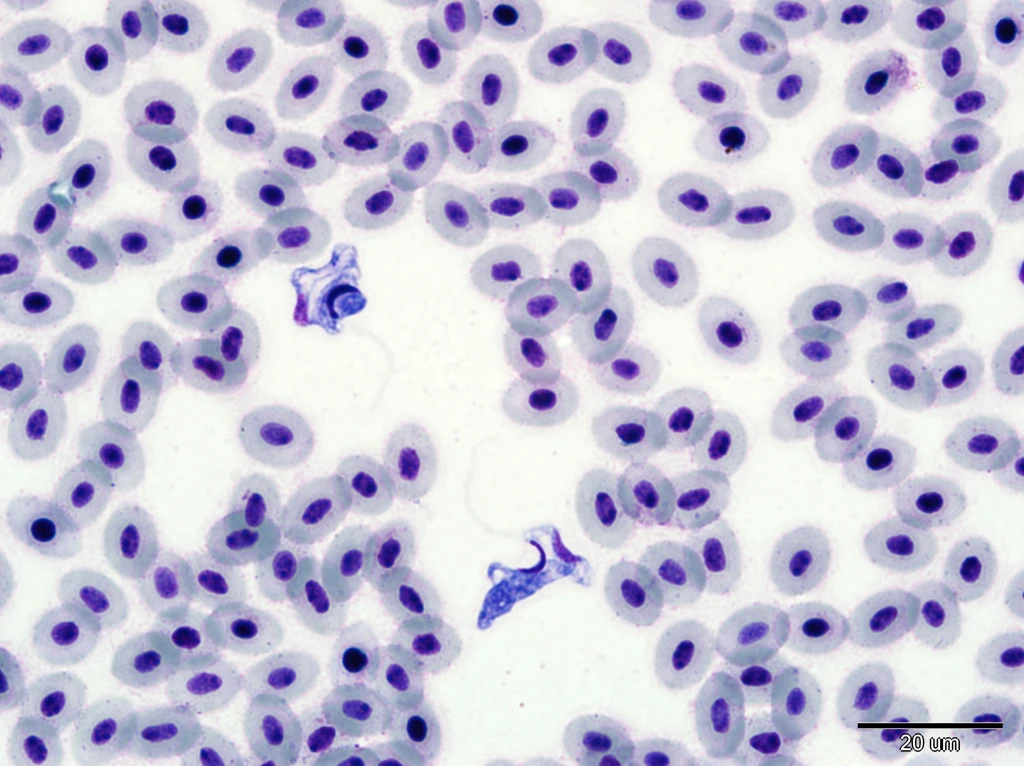
Bičíkovci rodu Trypanoplasma v krevním nátěru. Foto Miroslava Palíková

Představujeme nemoc: Krev není voda – pijavky a jejich neviditelní cestující
Tex a foto: Ivana Papežíková, Ivana Mikulíková, Miroslava Palíková
V České republice se podle posledních výzkumů vyskytuje 24 druhů pijavek. Tito živočichové většinou budí v lidech odpor a jsou považováni za krvelačná stvoření. Ve skutečnosti se většina našich druhů pijavek krví neživí – loví drobné bezobratlé živočichy, například vodní plže, nitěnky nebo larvy pakomárů. Jedinou naší pijavkou živící se krví savců včetně člověka je známá pijavka lékařská (Hirudo medicinalis), která je u nás dnes vzácná. Člověk se tedy pijavek nemusí příliš obávat. Zcela jiná situace je u ryb, protože většina z našich druhů sajících krev parazituje právě na nich.
Nejrozšířenější pijavkou napadající ryby je u nás chobotnatka rybí (Piscicola geometra). Tato pijavka žije ve stojatých i tekoucích vodách a je schopna parazitovat na více než třiceti druzích ryb. Má štíhlé válcovité tělo o délce až 6 cm, s okrouhlou přísavkou na předním i na zadním konci. Přední přísavka obklopuje ústní ústrojí uzpůsobené k probodnutí kůže a k sání krve. Na „hlavovém“ konci těla jsou čtyři čárkovité oční skvrny. Tělo je zbarveno šedohnědě se světlejšími příčnými skvrnkami a proužky. Pijavky patří mezi hermafrodity, každý jedinec má vyvinuty samčí i samičí pohlavní orgány. K rozmnožování jsou však vždy potřeba dva jedinci, kteří si navzájem předají spermie. V opasku kolem těla shromažďují oplozená vajíčka, která se následně uvolňují chráněná v kokonu. Dospělé pijavky po uvolnění kokonů hynou, mladé pijavky po vylíhnutí aktivně vyhledávají hostitele. Během roku se vyvíjejí 3−4 generace. Poslední generace dospělých jedinců přežívá zimu a koncem zimy nebo začátkem jara založí další generaci.

Rybí upíři
Při vyhledávání hostitele reagují pijavky na chemické signály, vibrace a proudění vody a využívají i svůj jednoduchý zrak (detekují stíny, které mohou znamenat přítomnost ryby). Buď jsou zadní přísavkou přichyceny k podkladu a jejich přední část těla volně vlaje ve vodě, anebo aktivně plavou. Po substrátu nebo po těle ryby se posunují píďalkovitým pohybem za využití obou přísavek. Na rybách se přisávají na povrch těla včetně očí a ploutví (obrázek 1 a 2), ale mohou se skrývat i v ústní nebo žaberní dutině.
Pijavky je možné odstranit z napadených ryb například hodinovou koupelí ryb ve 2,5% roztoku kuchyňské soli. Pijavky se ve slané vodě pustí hostitele, ale neuhynou. Počty pijavek v rybnících je možné redukovat odstraňováním příbřežní vegetace anebo důkladným vysušením a dezinfekcí dna.
Neviditelní pasažéři
Samotné sání krve pijavkami většinou rybám nezpůsobuje vážné potíže, jeho dopad závisí na velikosti ryby a na množství přisátých parazitů. V místech po odpadlých pijavkách však zůstávají otevřené ranky, které se mohou zaplísnit nebo být sekundárně infikovány bakteriemi. Dalším rizikem spojeným s napadením pijavkami je přenos krevních parazitů – bičíkovců rodu Trypanosoma a Trypanoplasma. Tito parazité mají složitý vývojový cyklus, který zahrnuje bezobratlého hostitele a obratlovce. U druhů napadajících ryby jsou bezobratlými hostiteli právě pijavky. Když pijavka nasaje krev infikované ryby, dostanou se bičíkovci do jejího trávicího traktu, kde se rozmnožují. Pak putují zpátky do ústního ústrojí, kde se hromadí a mohou zde zůstat infekční až několik měsíců. Když se pijavka přisaje na další rybu, bičíkovci se dostanou do její krve a do vnitřních orgánů, kde se začnou intenzivně dělit. Dochází k poškozování krevních buněk a k narušení krvetvorby, což vede k anémii a k oslabení imunity. Závažnost infekce závisí na množství bičíkovců přítomných v těle. Při silných infekcích jsou napadené ryby apatické, přestávají přijímat potravu, zvedají se ode dna, shromažďují se v místech s kyslíkatější vodou a ztěžka dýchají. Později zůstávají ležet u dna a hynou. Přes zimu se ryby málo pohybují, což usnadňuje napadení pijavkami, onemocnění proto většinou vrcholí koncem zimy.
Bičíkovce je možné prokázat mikroskopickým vyšetřením kapky čerstvé krve, vyšetřením krevního nátěru (obrázek 3) anebo speciálními laboratorními metodami. I když onemocnění správně diagnostikujeme, nemáme moc možností zasáhnout, protože účinný lék pro ryby zatím neexistuje. Preventivně se doporučuje tlumit výskyt pijavek a snížit tak riziko přenosu bičíkovců.